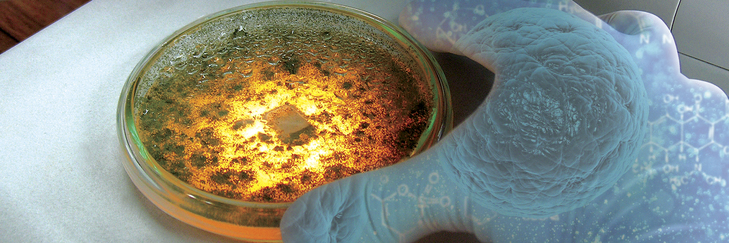
NanoBioCáncer

Por una Colombia Científica. Cumbre nacional
Minciencias, en alianza con Mineducación, Mincomercio e Icetex, realizarán el próximo 2 de diciembre a la Primera Cumbre Colombia Científica, espacio virtual para la presentación, análisis y discusión alrededor de resultados y contribuciones de los programas de investigación ejecutados por alianzas estratégicas para el desarrollo sostenible del país.

En este escenario virtual estarán el presidente de la República, Iván Duque Márquez y ministros del Gobierno; contará, además, con la participación del vicepresidente para América Latina y el Caribe del Banco Mundial, Carlos Felipe Jaramillo; la vicepresidenta Marta Lucía Ramírez y expertos científicos nacionales e internacionales, así como representantes de la academia y sector productivo.
Como resultado de esta alianza interinstitucional, 148 actores que participan en 8 ecosistemas científicos en los focos estraégicos: Bioeconomía, Salud, Energía Sostenible, Alimentos y Sociedad, presentarán los resultados e impactos logrados para el fortalecimiento institucional como aporte al país y en especial su papel potencial en la reactivación económica.
Las alianzas, conformadas por 58 Instituciones de Educación Superior públicas y privadas, 31 organizaciones del sector productivo y no académicas colombianas y 59 instituciones de educación y centros de investigación internacionales, han desarrollado más de 900 productos entre patentes, prototipos, plantas de bioprocesos, registros de diseños industriales, plataformas sensoras, la constitución de empresas (Spin-off), montaje de microplantas solar-eólica, creación de laboratorio de diseño de biofármacos, entre otros.

Durante la Cumbre Colombia Científica, los asistentes podrán participar en 4 foros temáticos: Ciencia + sociedad = Inclusión e innovación; Biodiversidad, Salud y Bioeconomía; Transición energética en Colombia: Logros, retos y oportunidades; y Seguridad, productividad y soberanía alimentaria desde el Agro.

El evento será el próximo miércoles, 2 de diciembre, a partir de las 8:45 a.m.
Mira la transmisión aquí
Por Minciencias. Agencia de Noticias UPB.